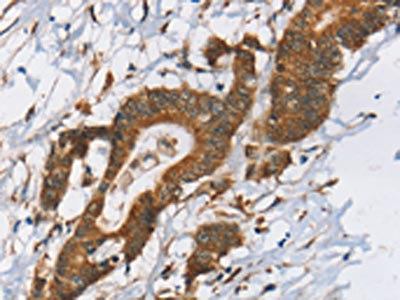

-
中文名稱:RPS6KA2兔多克隆抗體
-
貨號:CSB-PA064210
-
規格:¥1100
-
圖片:
-
The image on the left is immunohistochemistry of paraffin-embedded Human liver cancer tissue using CSB-PA064210(RPS6KA2 Antibody) at dilution 1/40, on the right is treated with synthetic peptide. (Original magnification: ×200)
-
The image on the left is immunohistochemistry of paraffin-embedded Human colon cancer tissue using CSB-PA064210(RPS6KA2 Antibody) at dilution 1/40, on the right is treated with synthetic peptide. (Original magnification: ×200)
-
-
其他:
產品詳情
-
Uniprot No.:
-
基因名:
-
別名:90 kDa ribosomal protein S6 kinase 2 antibody; HU 2 antibody; KS6A2_HUMAN antibody; MAP kinase activated protein kinase 1c antibody; MAP kinase-activated protein kinase 1c antibody; MAPK-activated protein kinase 1c antibody; MAPKAP kinase 1c antibody; MAPKAPK-1c antibody; MAPKAPK1C antibody; Mitogen.activated protein kinase-activated protein kinase 1C antibody; p90 RSK3 antibody; p90-RSK 2 antibody; p90RSK2 antibody; pp90RSK3 antibody; Ribosomal protein S6 kinase alpha-2 antibody; ribosomal protein S6 kinase; 90kDa; polypeptide 2 antibody; Ribosomal S6 kinase 3 antibody; RPS6KA2 antibody; RSK 3 antibody; RSK antibody; RSK-3 antibody; S6K alpha antibody; S6K alpha 2 antibody; S6K-alpha-2 antibody
-
宿主:Rabbit
-
反應種屬:Human,Mouse
-
免疫原:Synthetic peptide of Human RPS6KA2
-
免疫原種屬:Homo sapiens (Human)
-
標記方式:Non-conjugated
-
抗體亞型:IgG
-
純化方式:Antigen affinity purification
-
濃度:It differs from different batches. Please contact us to confirm it.
-
保存緩沖液:-20°C, pH7.4 PBS, 0.05% NaN3, 40% Glycerol
-
產品提供形式:Liquid
-
應用范圍:ELISA,IHC
-
推薦稀釋比:
Application Recommended Dilution ELISA 1:2000-1:5000 IHC 1:50-1:200 -
Protocols:
-
儲存條件:Upon receipt, store at -20°C or -80°C. Avoid repeated freeze.
-
貨期:Basically, we can dispatch the products out in 1-3 working days after receiving your orders. Delivery time maybe differs from different purchasing way or location, please kindly consult your local distributors for specific delivery time.
-
用途:For Research Use Only. Not for use in diagnostic or therapeutic procedures.
相關產品
靶點詳情
-
功能:Serine/threonine-protein kinase that acts downstream of ERK (MAPK1/ERK2 and MAPK3/ERK1) signaling and mediates mitogenic and stress-induced activation of transcription factors, regulates translation, and mediates cellular proliferation, survival, and differentiation. May function as tumor suppressor in epithelial ovarian cancer cells.
-
基因功能參考文獻:
- Data suggest that millisecond dynamic changes in PDZ1 domain conformation are responsible for higher affinity of scribble PDZ1 for phosphorylated ligands; oligopeptide fragments of RPS6KA2 and MCC were used as ligands in these nuclear magnetic resonance chemical shift experiments. (RPS6KA2 = ribosomal protein S6 kinase 2; MCC = mutated in colorectal cancer protein) PMID: 29144123
- Data indicate that S6 kinase 2 (S6K2) can phosphorylate histone H3 at position Thr45, which may play a role during cell proliferation and/or differentiation. PMID: 23564320
- Kinome screening revealed RPS6KA2 expression, in human pancreatic cancer cells, protects against erlotinib induced apoptosis. PMID: 24403857
- genetic association study in Han population in China: Data suggest that SNPs in RSK3 (rs2229712) and in MEK1 (rs28730804) demonstrate gene-gene interaction that affects antidepressant drug outcome in female patients with major depressive disorder. PMID: 23727904
- Overexpression of RSK3 or RSK4 supports tumor cell proliferation upon PI3K inhibition both in vitro and in vivo therby contributing to drug resistance. PMID: 23635776
- p90RSK2 is dispensable for BCR-ABL-induced myeloid leukemia, but may be required for pathogenesis and lineage determination in FLT3-internal tandem duplication-induced hematopoietic transformation. PMID: 21527514
- Characterization of the terminal domain as a protein kinase PMID: 12016217
- chronic activation CREB and p90RSK in the epileptic hippocampus may be closely associated with the histopathological changes of Ammon's horn sclerosis PMID: 14646589
- The accumulation of S6K2 in the nuclei of cancer cells and the correlation with the expression of PCNA and Ki-67 suggest the involvement of S6K2 in the regulation of malignant growth PMID: 15995633
- p90Rsk-mediated modulation of Hdm2 nuclear is linked to cytoplasmic shuttling with the diminished ability of p53 to regulate cell cycle checkpoints that ultimately leads to transformation PMID: 16621805
- The above results suggest that RPS6KA2 is a putative tumour suppressor gene to explain allele loss at 6q27. PMID: 16878154
- there is a functional link between S6K1 II and CK2 signaling, which involves the regulation of S6K1 II nuclear export by CK2-mediated phosphorylation of Ser-17 PMID: 16895915
顯示更多
收起更多
-
亞細胞定位:Nucleus. Cytoplasm.
-
蛋白家族:Protein kinase superfamily, AGC Ser/Thr protein kinase family, S6 kinase subfamily
-
組織特異性:Widely expressed with higher expression in lung, skeletal muscle, brain, uterus, ovary, thyroid and prostate.
-
數據庫鏈接:
Most popular with customers
-
-
Phospho-YAP1 (S127) Recombinant Monoclonal Antibody
Applications: ELISA, WB, IHC
Species Reactivity: Human
-
-
-
-
-
-